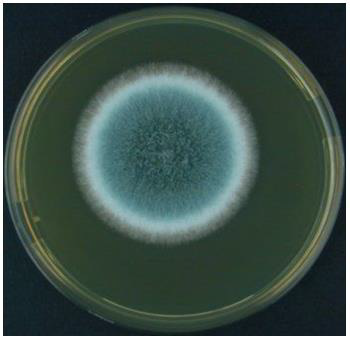

Case Report
Creative Commons, CC-BY
Aspergillus fumigatus and Aspergillosis
*Corresponding author: Khayria M Abdel-Gawad, Department of Botany and Microbiology, Faculty of Science, Assiut University, Egypt.
Received: November 01, 2021; Published: November 23, 2021
DOI: 10.34297/AJBSR.2021.14.002043
Keywords: Aspergillus fumigatus, Aspergillosis, Pulmonary Aspergillosis, Allergic pulmonary aspergillosis, Aspergilloma, Cutaneous aspergillosis
Introduction
Aspergillus species are saprophytic fungi distribute everywhere in the environment in the air, soil, on the surfaces, on plant leave surfaces and plant debris. While the saprophytic nature of Aspergillus spp means they fully depend on environmental materials [1], which allows them to produce enzymes [1,2]. Also, it is a spore-forming mold fungus reproduces asexually by producing spores in the form of conidia. Therefore, the conidial spores are densely produced into the air during sporulation and are consistently inhaled by humans and animals in hundreds per day [2]. For instance, the direct inoculation of the skin surgical wounds, and burns as result of dissemination [3]. The incidence of infection may be severely in immunosuppressed patients [3]. That it can be pathogenic in humans causing severe allergic reactions and respiratory opportunistic fungal infection known as aspergillosis especially in immune-compromised individuals [2]. Aspergillosis in its most significant form is an infectious disease caused by Aspergillus spp [3,4].
It is usually confined to the lungs, but sometimes spreads to other organ systems [3]. Also, the conidia of Aspergillus fumigatus have the ability to evade the innate immune defenses by cilia and the mucosal lining of the respiratory tract. Therefore, the conidia first start to invade the outer blood vessels, moving through the endothelial cells into the inner part of the blood vessels during growth of hyphae. However, signs and symptoms include asthma, pneumonia, sinusitis, or rapidly progressing systemic illness [5]. It was also found that, Aspergillus Flavus was the second common etiological agent of invasive aspergillosis (IA) after Aspergillus fumigatus [6]. However, most literature describes IA in relation to Aspergillus fumigatus or together with other Aspergillus species causes the diseases. On the other hand, a broad spectrum of human diseases is caused by Aspergillus Flavus in Asia, the Middle East, and Africa, compared to other Aspergillus spp may be due to its ability to survive better in hot and arid climatic conditions [6]. It was found that echinocandins is not the first choice but the combination with voriconazole or as monotherapy may be used when the azoles and amphotericin B are contraindicated [6].
Characteristics of Aspergillus fumigatus
Aspergillus fumigatus description due to Raper and Fennell [7]. Colonies reaching 7 cm diam. In ten days at 24-26oC. on Czapekes spreading broadly, thin, bluish green, with strictly columnar conidial heads. Pigmented conidiophores with clavate vesicles arising from clearly differentiated thick-walled foot cells. Conidia globose to subglobose, echinulate, mostly 2.5-3.0 diam. Aspergillus fumigatus is a thermo tolerant fungus with a worldwide distribution. Due to a rather wide temperature range for good growth. It has been reported as air spora and numerous finds in forest soils. It has a high competitive saprophytic ability. Aspergillus fumigatus is characterized by the ability to grow in the range between 12oC and 57oC with an optimum between 37oC and 43oC. It tolerates temperatures during pasteurization to 63oC for 25 min [8] and (Figure 1 & 2).
Scientific Classification
Kingdom of Fung (Mycota) (Table 1 & Figure 3).
Reproduction of Aspergillus fumigatus
Aspergillus fumigatus reproduce only by asexual means [9] (Figure 3). While sexual stage for A. fumigatus was suggested that may identified yet be [4]. Typical of the supposedly ‘asexual’ fungi are many species of Aspergillus. The genus contains some 182 species and includes taxa with homothallic (selfing) and heterothallic (obligate outcrossing) sexual breeding systems. For instance, the majority of species are known to reproduce only by asexual means [10]. Asexual reproduction occures by the formation of foot cell produces a special erect branch known as conidiophore.
The tip of the conidiophore swells up into on elliptical or globular multinucleate head called as vesicle [11]. It forms many radially arranged tubular outgrowths called sterigmata or phialides. The conidia when disseminate germinate by the formation of hypha. In some species primary sterigmata (uniseriate) bear secondary sterigmata. (Bi-seriate) [11] (Figure 4).
Aspergillosis
Aspergillosis is an infectious disease caused by Aspergillus spp., it is usually confined to lungs, but sometimes spreads to other organ systems. The clinical types of aspergillosis are pulmonary aspergillosis including colonizing, allergic, aspergilloma. Miscellaneous forms of aspergillosis are otomycosis, cutaneous aspergillosis and onychomycosis [3].
Pulmonary Aspergillosis
Colonizing pulmonary Aspergillosis: Aspergillus spp. may be isolated from sputum of patients with chronic lung disease, the bronchopulmonary surfaces appear to be colonized by Aspergillus fumigatus [3].
Allergic Pulmonary Aspergillosis
Extrinsic allergic alveolitis is a hypersensitivity pneumonia that occures in individuals exposed to large numbers of Aspergillus elements. For example, is the farmers’ lung that follows exposure to moldy grains [3].
Symptoms
Malaise, chills, fever, cough, dyspnea and myalgia. Granulomatous disease and pulmonary fibrosis as a result of repeated infection [3].
Allergic Bronchopulmonary Aspergillosis
Is a hypersensitivity reaction to colonization of bronchial tree by Aspergillus fumigatus [3].
Aspergilloma (Fungus Ball)
Is the most common of the noninvasive pulmonary Aspergillus infections. That Aspergillus fumigatus takes up residence in a lung cavity produced by preexisting disease, particularly, tuberculosis, histoplasmosis and sarcoidosis. Aspergillus fumigatus multiple in lung cavity and produce a mycelial mass referred to fungus ball, Signs and symptoms may be absent for years, but in some cases blood vessels in the cavity wall lead to hemoptysis and hemorrhages that may be sever [3] (Figure 5 & 6 & 7).
Cutaneous Aspergillosis
Aspergillus skin infections may be primary the result of traumatic or iatrogenic implantation of the organism in the skin [3].
Onychomycosis
Aspergillus terreus (Figure 8 & 9) sometimes causes onychomycosis. The nail plate is involved and show peripheral greenish discoloration or white spots (Figure 10 & 11). Aspergillus Niger also has been isolated from pulmonary infections and cutaneous aspergillosis, and the most common cause of otomycosis [3] (Figure 12 & 13). A. flavus sometimes causes pulmonary, nasalorbital, corneal and otomycosis [3]. A. flavus group due to Raper and Fennell [8] Colonies 3-7cmm diam. In ten days at 24-26oC on Cz medium. Yellow green in color. Conidiophores hyaline, 0.4-1 mm long with rough wall. Conidial heads radiating, conidia globose to subglobose roughened to echinulate mostly 3.5-4.5 diam. Some isolates produce light to dark red and brown sclerotia. It was found that 50% of A. flavus species produces aflatoxins. It can cause pulmonary infections in birds [7].
Treatment
Systemic corticosteroids are indicated in controlling the disease. Amphotericin B has been the drug for invasive aspergillosis , also, is used for zygomycosis. Nystatin and aluminum subacetate solution Burows ssolution.are used for Aspergillus otomycosis. Application of nystatin and thymol iodide for onychomycosis [3].
Conclusions
Aspergillus fumigatus is a saprobe and weak opportunistic fungus, that spreads by its conidia in the air especially in the fields where the fungus grows on infectious grains, or on plant debris that the conidia inhaled by humans and causes severe allergic reactions and respiratory opportunistic fungal infection known as Aspergillosis, especially in immune-compromised individuals. Inhalation of airborne Aspergilla’s conidia is the initial event in pulmonary aspergillosis and dissemination of infection.
Conclusions
Table 2: Indicators of the reproductive function of rabbits with weekly cutaneous exposure and 0.03% dust-esfenvalerate at a dose of 20g / bird.
Table 3: Indicators of the reproductive function of rabbits with weekly cutaneous exposure and 0.03% dust-esfenvalerate at a dose of 20g / head and treated with the drugs “Gamavit” and “Mexidol”.
References
- Jean-Paul Latgé (1999) Aspergillus fumigatus and Aspergillosis). Clin Microbiol Rev. 12(2): 310–350.
- Faith Mokobi (2021) Aspergillus fumigatus- An Overview.
- John Thorne Crissey, Heidi Lang, Lawrence Charles Parish (1995) Manual of medical mycology. B Blackwell Science 1-263.
- Español (Spanish) (2012) Aspergillosis. Fungal Diseases. Centers for diseases control and prevention.
- Sanjay G Revankar (2021) Aspergillosis, Wayne State University School of Medicine.
- Shivaprakash M Rudramurthy, Raees A Paul, Arunaloke Chakrabarti, Johan W Mouton, Jacques F Meis, et al. (2019) Invasive Aspergillosis by Aspergillus flavus: Epidemiology, Diagnosis, Antifungal Resistance, and Management. J Fungi (Basel) 5(3): 55.
- Domsch KH and Gams W (1980) Compendium of soil fungi volume 1. Book of Academic press. London New York, USA.
- Raper KB, Fennell DI (1965) The genus Aspergillus. Williams and Wilkins, company Baltimore, Maryland. Pp. 686
- Dyer PS, Paoletti M (2005) Reproduction in Aspergillus fumigatus: sexuality in a supposedly asexual species? Med Mycol 43 Suppl: S7-S14.
- Paul S Dyer and Céline M O Gorman (2012) Sexual development and cryptic sexuality in fungi: insights from Aspergillus species.
- Shagun Khande, Aspergillus Habitat, Reproduction and Importance | Ascomycotina.

We use cookies to ensure you get the best experience on our website.